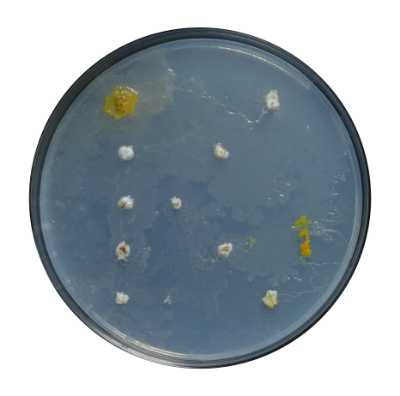

THIS PROECT AIMED TO GIVE SLIME MOLD THE BLOB THE SPACE TO DEVELOP ITS PROPER ALPHABET
THE MICRO-CULTURES WERE PRESENTED WITH A BASIC STRUCTURE OF THE LATIN CHARACTERS AS OAT FLAKES CREATED WITHIN A FIVE BY FIVE OR NINE BY NINE GRID SYSTEM PLACED WITHIN AGAR FILLED PETRI DISHES TO PROVIDE THE MOISTURE NEEDED FOR THE MICROORGANISM TO STAY ACTIVE THE BLOB NAVIGATED AROUND THE AGAR DISH SEARCHING FOR NUTRITION LEAVING SELFPRODUCED NONLIVING EXTRACELLULAR SLIME TRAILS CREATING A NEW ALPHABET SINGULAR TO THE SLIME MODE CULTURE IN USE

A HUGE THANKS GOES TO